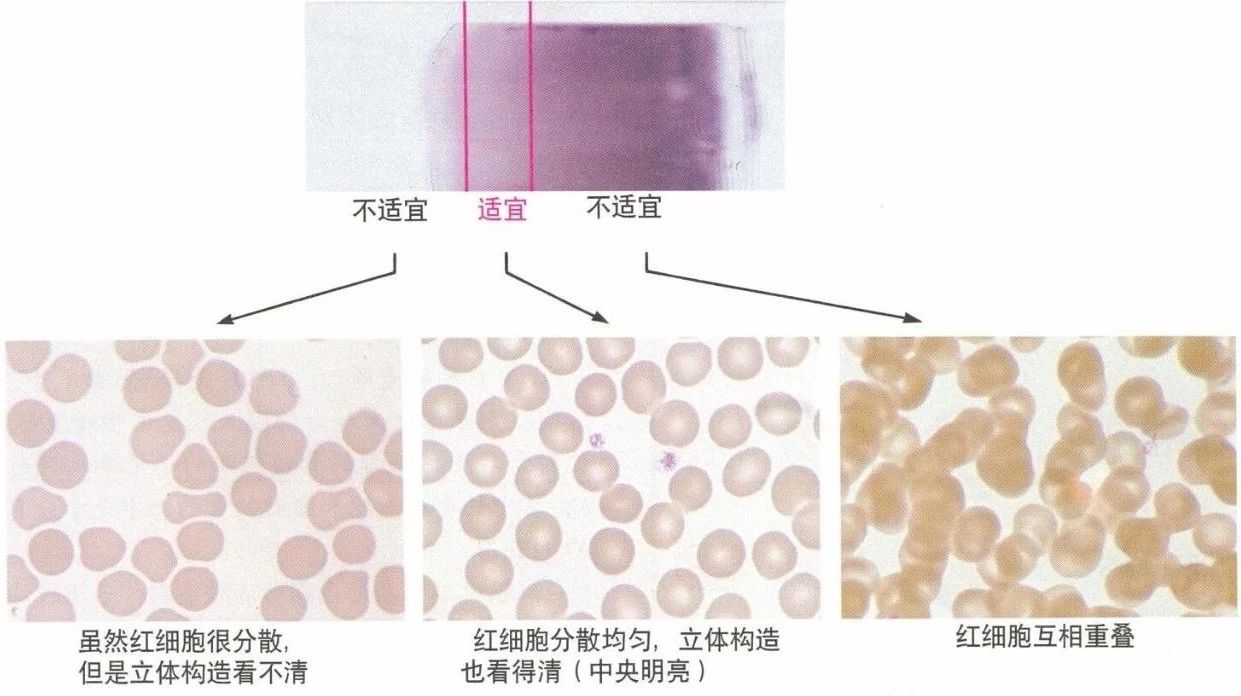

血涂片看似很基本,却是技术活。做好血液涂片和正确染色是血液细胞检验的重要步骤,涂片和染色效果的好坏直接关系着检验的结果,必须以认真负责的态度注意操作过程的每一个环节。没有制备/染色良好的血涂片,想正确识别血细胞无异于天方夜谭。
参考人民卫生出版社《临床检验基础》、《临床基础检验学技术》教材、中华人民共和国卫生行业标准(白细胞分类计数参考方法)(WS/T 246-2005),整理血涂片的制备/染色/观察方法,仅供战友学习参考。
一、载玻片的要求
载玻片是用显微镜观察东西时用来放东西的玻璃片或石英片,呈长方形,大小为76*26 mm,较厚,透光性较好。使用时可将玻片放入肥皂或洗衣粉水中煮沸20 分钟,再用自来水洗去肥皂和血膜等污物,最后再用蒸馏水冲洗3 ~5 次。必要时再置95%乙醇中浸泡1小时,然后擦干或烘干备用,彻底清洗游离碱质。
二、血涂片制备方法
血涂片是血液细胞学检查的基本方法,应用极广。特别是对各种血液病的诊断有很大价值。但血片制备和染色不良,常使细胞鉴别发生困难,甚至导致错误结论。
常规使用薄血膜退片法,可分为采血、制备血涂片、干燥三个步骤,如下所示:

涂片的厚薄与血滴大小、推片与载玻片间夹角、推片速度、血细胞比容有关。

值得一提的是取血量:

左侧小血滴是5ul的,右侧大血滴是50ul的。
不少资料都在这里犯了错误,比如全国临床检验操作规程第3版/第4版都说取0.05ml血(50ul),从上图不难看出,这么多血是不可能制备出良好血涂片的;推荐取5ul左右,最好是不抗凝的静脉血或者手指血;EDTA抗凝血也可用,但并不是最好的选择。

三、良好血涂片的标准
由厚到薄均匀过渡,厚薄适宜,头/体/尾分明,分布均匀,边缘整齐,两侧留有空隙,末端呈方形或羽毛状,无粒状/划线或裂隙(会使白细胞分布不均匀,集中在这些区域内)。

血涂片外观应头、体、尾分明,分布均匀,边缘整齐,两侧留有空隙。

四、血涂片的染色
(一)染料
1、瑞氏染色法:
①瑞氏染料由酸性染料伊红(E-)和碱性染料亚甲蓝(M+)组成。
②染色原理:
既有物理的吸附作用,又有化学的亲和作用。各种细胞成分化学性质不同,对各种染料的亲和力也不一样,可根据染色来判断细胞。
2、吉姆萨染色法:
染色原理与瑞氏染色法大致相同。吉姆萨染料由天青和伊红组成。本法对细胞核和寄生虫着色较好,结构显示更为清晰,但细胞质和颗粒着色较差。
3、瑞氏-吉姆萨复合染色法:
兼顾两者之长,将瑞士染粉和吉氏染粉混合,用甲醇溶解即瑞-吉液,用瑞-吉液进行染色,使血细胞的颗粒及细胞核均能获得满意的染色效果。

(二)染色方法
瑞氏/瑞吉染色方法:待血涂片干透后,用蜡笔在其两端划线,以防染色时染液外溢。具体如下所示:

五、血涂片染色良好的特征
染色良好的血膜片,外观呈浅红色,红细胞呈粉红色,白细胞核呈暗紫红色, 染色质结构能辨,粒细胞的颗粒呈固有种异颜色。
染色时间应视具体情况而定,特别是更换新染料时必须经试染,摸索最佳染色条件。
六、血涂片检查步骤
1、首先在低倍镜下(10倍~40倍)进行浏览,观察有无异常细胞和细胞分布情况。然后,在100倍油镜下,观察细胞浆内的颗粒和核分叶情况。
2、检查从约50%的红细胞互相重叠区域开始,向红细胞完全散开的区域推移。血涂片较薄的区域,呈羽毛状,为“血片边缘”。
3、中性粒细胞,单核细胞和淋巴细胞分布均匀的区域为血涂片分类“可接受”区域。当白细胞总数正常时,在血涂片尾部和边缘,每油镜视野所见的白细胞数量不超过血涂片体部的2~3倍。
4、除某些病理情况(如慢性淋巴细胞白血病)外,破碎细胞或不能识别细胞的数量不超过白细胞总数的2%。若破碎细胞仍能明确鉴别(如破碎的嗜酸性粒细胞)应包括在分类计数中。在结果报告中,应设其他栏,以备填写破碎细胞或不能识别细胞,并作适当描述。
5、计数方法
(1)采用“城垛式”方法检查血涂片(图1)。每个明确识别的细胞必须归入下列分类中:中性分叶核粒细胞;中性杆状核粒细胞;淋巴细胞;异型淋巴细胞;单核细胞;嗜酸性粒细胞;嗜碱性粒细胞;其他有核细胞(除有核红细胞外)。能明确识别的破碎细胞,应恰当分类。

【笔者注】实际工作中,有些同行习惯这样检查血涂片:

这也是可以的。
(2)每张血涂片应计数200个白细胞,若样本中白细胞数量减少,应增加检查血涂片的数量。
【笔者注】不过,一般的教科书的要求如下:

所以,并不是一定要计数200个白细胞
(3)白细胞分类结果以百分率和绝对值表示。
(4)计数所有的有核红细胞,结果以每100个白细胞计数中见到几个表示。来源:UJS医学检验毕业生、检验星空